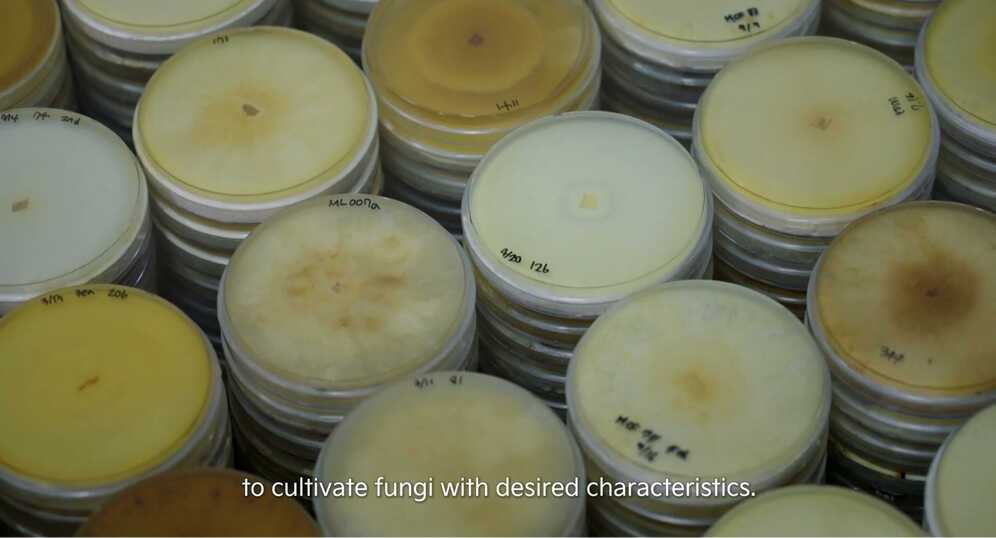
nationalgeographic_5.jpg

자연에서 영감을 받은 기아의 혁신
기아는 자연에서 영감을 받은 혁신으로 자연을 지키고 있습니다.
“자연은 다양한 문제에 대한 해답을 제시합니다.” 구조 엔지니어, 건축가이자 <내셔널 지오그래픽>의 탐험가로 활동 중인 ‘아서 황(Arthur Huang)’의 말입니다. 기아 또한 자연에서 얻은 영감을 디자인, 기술, 지속가능성 등 다양한 부분에 활용하고 있죠. 그래서 기아에게 자연은 가장 위대한 혁신의 원천이자 지켜야 할 대상입니다. 기아가 아서 황과 여정을 함께 하며, 자연으로부터 영감을 받은 혁신적인 기술과 아이디어를 소개한 이유도 바로 이 때문이죠. 기아가 아서 황과 함께 전하고 싶었던 이야기를 소개합니다.

자연은 경이로움으로 가득합니다. 작은 버섯 하나에서도 혁신의 실마리를 찾아낼 수 있죠. 버섯으로 단단한 벽돌과 자동차 시트를 만들 수 있다면 어떨까요? 이를 위해서는 먼저 버섯의 구조를 확인할 필요가 있습니다. 버섯은 자실체(子實體, Fruit body)와 균사체(菌絲體, Mycelium)로 이루어져 있습니다. 자실체는 우리가 먹는 버섯의 갓과 몸통이고, 균사체는 버섯 아래 뿌리입니다. 즉, 일반적인 식물과 비교하면 자실체는 꽃이나 열매라고 할 수 있으며 균사체는 영양분을 만들고 흡수하는 뿌리, 줄기, 잎과 비교할 수 있습니다.

균사체는 영양분을 섭취하기 위해 분해 물질을 배출합니다. 이는 플라스틱, 스티로폼, 석유 외에도 염료, 살충제 등 다양한 오염 물질을 분해하는 효과가 있습니다. 아울러 여기서 얻은 영양분을 먹고 크는 균사체를 이용하면 다양한 모양의 재료를 만들 수 있습니다. 가령 네모난 모양의 구조물을 만들기 위해서는 네모난 모양의 폐기물 내에 균사체를 퍼트리면 됩니다. 균사체가 기존 분해물을 분해하면서 성장해 내부 공간을 채우기 때문입니다.

또한 균사체는 가공 방법에 따라 여러 용도로 활용이 가능합니다. 기아가 균사체를 이용해 만든 가죽 대체품이 좋은 예입니다. 다양한 질감을 모방할 수 있고, 염색도 가능해 실내 곳곳에 쓸 수 있습니다. 특히 찢어짐에 강하고 인장 강도가 높다는 특징 덕분에 오랜 기간 사용되는 자동차 시트에 적격입니다.

기아가 만든 균사체를 이용한 가죽 대체품은 제작과 폐기 과정 모두 친환경적입니다. 천연 가죽 시트와 비교하면 제조 과정에서 사용하는 물의 양이 훨씬 적으며 폐기할 때도 자연 분해가 됩니다. 특성 조절이 쉽다는 것도 빼놓을 수 없는 특징입니다. 감자 껍질이나 나무 등 균사체가 소화하기 어려운 물질을 사용하면 한층 단단한 균사체를 만들 수 있습니다.

미국 국방고등연구계획국(DARPA, Defense Advanced Research Projects Agency) 또한 균사체에 많은 관심을 갖고 있습니다. 허리케인 등의 자연재해 이후 지역 재건에 사용하기 위해서죠. 이런 대규모 공사에서 필요 자재를 외부에서 수급하면 효율성이 떨어집니다. 하지만 현지에서 균사체를 이용해 직접 자재를 만들면 시간과 비용을 절감할 수 있습니다. 게다가 균사체를 활용하면 자가수복(스스로 원래 모습으로 복구)이 가능한 건물을 만들 수도 있습니다.

이처럼 균사체의 활용 방안은 다양합니다. 기아가 균사체의 가능성을 실험하는 이유죠. 특히 제작과 폐기를 반복하는 나쁜 습관에서 벗어날 수 있다는 것이 중요합니다. 기존의 재료를 효과적으로 다시 활용할 수 있다는 점은 인류의 지속가능성에 긍정적인 영향을 미칩니다.

기아는 바다에서도 지속가능성의 영감을 얻고 있습니다. 바다는 생명이 순환하는 거대한 생태계입니다. 바다에서 태어난 생명체는 바다에서 죽지만, 다른 생물들의 에너지원이 됩니다. 버리는 것이 없는 거대한 순환 시스템이라고 할 수 있죠. 하지만 플라스틱 등 인류가 만든 폐기물이 해양을 오염시키고 있습니다. 플라스틱은 화학적으로 분해되지 않기 때문에 바다를 떠다니다 파편화되고 미세 플라스틱이 됩니다.

다행히 전세계 많은 국가가 재활용 프로그램을 강화하며 폐기물 문제에 대한 인식이 개선되고 있습니다. 하지만 아직도 갈 길은 멉니다. 플라스틱 대부분이 여전히 재활용되지 못하고 매립지나 소각장으로 보내지고 있습니다. 플라스틱과 같은 악성 폐기물을 다른 나라로 보내는 국가도 아직 많습니다. 운송과정에서 탄소를 배출하기에 현지에서 재활용하는 것보다 환경에 미치는 영향이 큽니다.

이에 주목한 아서 황은 바다에서 건져낸 플라스틱을 건축의 일부로 활용하거나, 분쇄하고 가공해 건축 자재로 활용하고 있습니다. 이는 인류에게 아주 중요한 활동이라고 할 수 있습니다. 해양 환경을 정화하는 것을 넘어 언젠가 폐기할 새 자재를 만드는 것이 아닌, 기존의 자재를 변형해 사용한다는 점에서 환경에 미치는 영향을 최소화할 수 있기 때문입니다.

기아 역시 해양 플라스틱 문제의 심각성을 인지하고, 해양 생태계 미치는 부정적인 영향을 줄여 지속가능한 미래를 만들기 위해 노력하고 있습니다. 해양과 강에서 플라스틱 및 쓰레기 정화 활동을 하는 네덜란드의 비영리단체 ‘오션클린업(The Ocean Cleanup)’과 파트너십을 체결한 것이죠. 기아는 오션클린업의 정화사업을 후원하고 있으며, 이를 통해 수거한 플라스틱을 재활용하여 제품에 적용할 계획입니다.

말 뿐인 재활용이 아닙니다. 가령 기아의 전용 전기차 EV6는 폐플라스틱 재활용 소재를 적극적으로 사용하고 있습니다. 플라스틱 병을 분쇄한 후 가공하여 만든 원사를 이용해 도어 포켓, 크래시패드 장식, 보조 매트 등에 활용했죠. 또한 신형 니로의 헤드라이닝(천장 마감재)은 부직포에 재활용 페트를 56% 섞어 가공한 것이며, 카고 스크린(짐 공간 가리개) 또한 니트 재질 안에 재활용 페트를 70% 섞어 제작했습니다.
자연은 다양한 가능성을 담고 있습니다. 아직 발견하지 못한 수많은 혁신이 자연 속에 숨어있습니다. 그래서 자연을 탐구하는 동시에 보호하는 일은 우리 모두를 위한 일이기도 합니다. 다음에는 또 어떤 지속가능한 혁신이 우리를 맞이할까요? 우리가 자연에서 영감을 받아 새로운 혁신을 선보이는 기아의 여정을 주목해야 하는 이유입니다.
현대자동차그룹 뉴스 미디어, HMG 저널 바로가기
